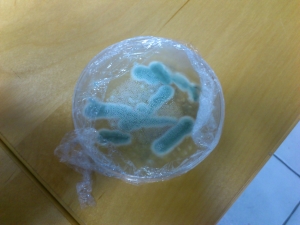

penicilinschimmel.jpg
Size of this preview: 300 × 225 pixels. Other resolutions: 30 × 22 pixels 75 × 56 pixels 150 × 112 pixels 225 × 168 pixels 300 × 225 pixels
olga:penicilinschimmel.jpg ( 300 × 225 pixels )
Information
| Date: | 2013-06-06 19:10 |
|---|---|
| Filename: | penicilinschimmel.jpg |
| Format: | JPEG |
| Size: | 51KB |
| Width: | 300 |
| Height: | 225 |
| Camera: | Sony Ericsson WT19i |
References for
This list might not be complete due to ACL restrictions and hidden pages.
- /srv/dokuwiki/data/pages/olga/projekte_penicillin_herstellen.txt
- Last modified: 2025-11-09 09:25
- by 127.0.0.1